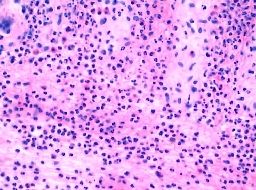

北京京城皮肤医院提供网络预约挂号服务
预约挂号热线:010-64888999
三级专科
医保定点
舒适环境
无假日
念球菌性皮炎的特点有什么?念球菌性皮炎严重困扰着我们身边的很多人,很多患者关心这个念球菌性皮炎问题,但目前有很多患者对念球菌性皮炎了解不足,错过了较佳念球菌性皮炎治疗时机,从而导致念球菌性皮炎情发展严重,增加了念球菌性皮炎患者痛苦,同时也增加了念球菌性皮炎的治疗难度。知道念球菌性皮炎的特点有什么,就可以及早的采取措施,预防念球菌性皮炎的发生。
很多患者都不知道,念球菌性皮炎的特点有什么?北京京城皮肤医院为您详细服务。
北京京城皮肤医院指出,念球菌性皮炎的特点有:念球菌性皮炎可同时侵犯口腔或外阴粘膜,常有乳酪样分泌物呈假膜状。念球菌性皮炎患者不同程度搔痒。直接镜检或培养可查到念珠菌。
北京京城皮肤医院已经对念球菌性皮炎的特点做出了简单的解释。 需要指出的是:念球菌性皮炎一经发现,应立即予以治疗,切莫耽误病情。
温馨提示:了解更多“念球菌性皮炎的特点”,可以选择预约专家预约,您将得到满意的答复。
推荐阅读:念球菌性皮炎的发病部位
推荐阅读:小儿念珠菌性皮炎的症状特点
推荐阅读:什么是念球菌性皮炎
推荐阅读:念球菌性皮炎症状图